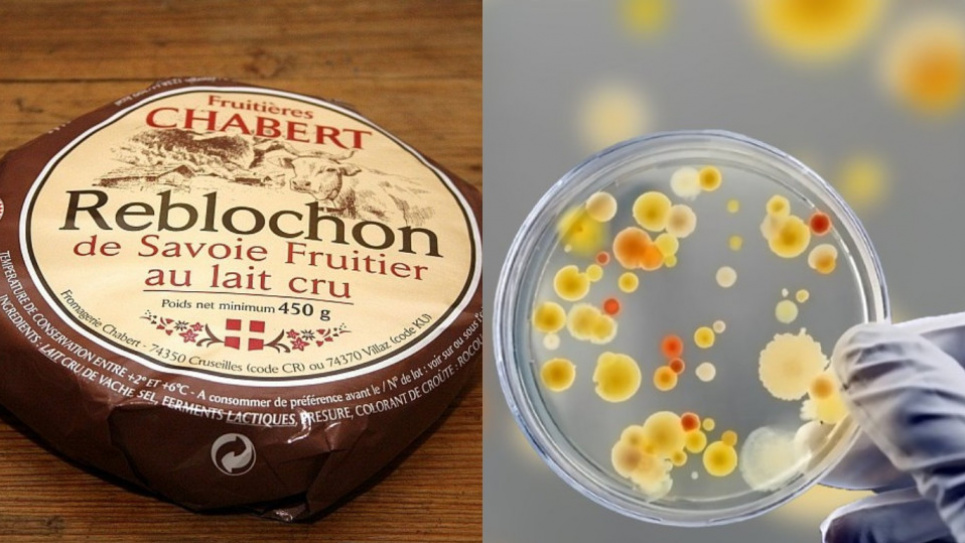

Є ризик захворіти на менінгіт: в українські магазини потрапив небезпечний сир
Може стати причиною зараження крові та менінгіту.
У роздрібні мережі України міг потрапити небезпечний сир із Франції під назвою Reblochon de Savoie, у якому було виявлено збудник стафілококової інфекції.
Потрапивши в організм збудник виділяє ентеротоксини, які стають причиною харчового отруєння у 90% споживачів. Сильне отруєння цими токсинами може спричинити серйозні захворювання, такі як:
- зараження крові,
- бронхіт,
- ендокардит,
- менінгіт.
За даними експертів RASFF – європейської системи швидкого сповіщення про небезпечну продукцію, французький сир Reblochon de Savoie виробляють кілька виробників, тому перевірки проводять у них усіх.
“У зараженій продукції виявлено збудник стафілококової інфекції. Зараз експерти досліджують усіх виробників цього сиру, щоб зробити свої висновки щодо зараженої продукції”, – повідомили експерти RASFF.
Як відомо, за частотою випадків саме стафілококове отруєння посідає перше місце серед харчових отруєнь. Причина його виникнення – потрапляння в організм ентеротоксину, що виділяється Staphylococcus aureus (Золотистий стафілокок).
Чутливість людини до ентеротоксину стафілокока дуже висока - отруєння настає у 90%, що вживали заражену їжу.
Більше новин читайте на GreenPost.







